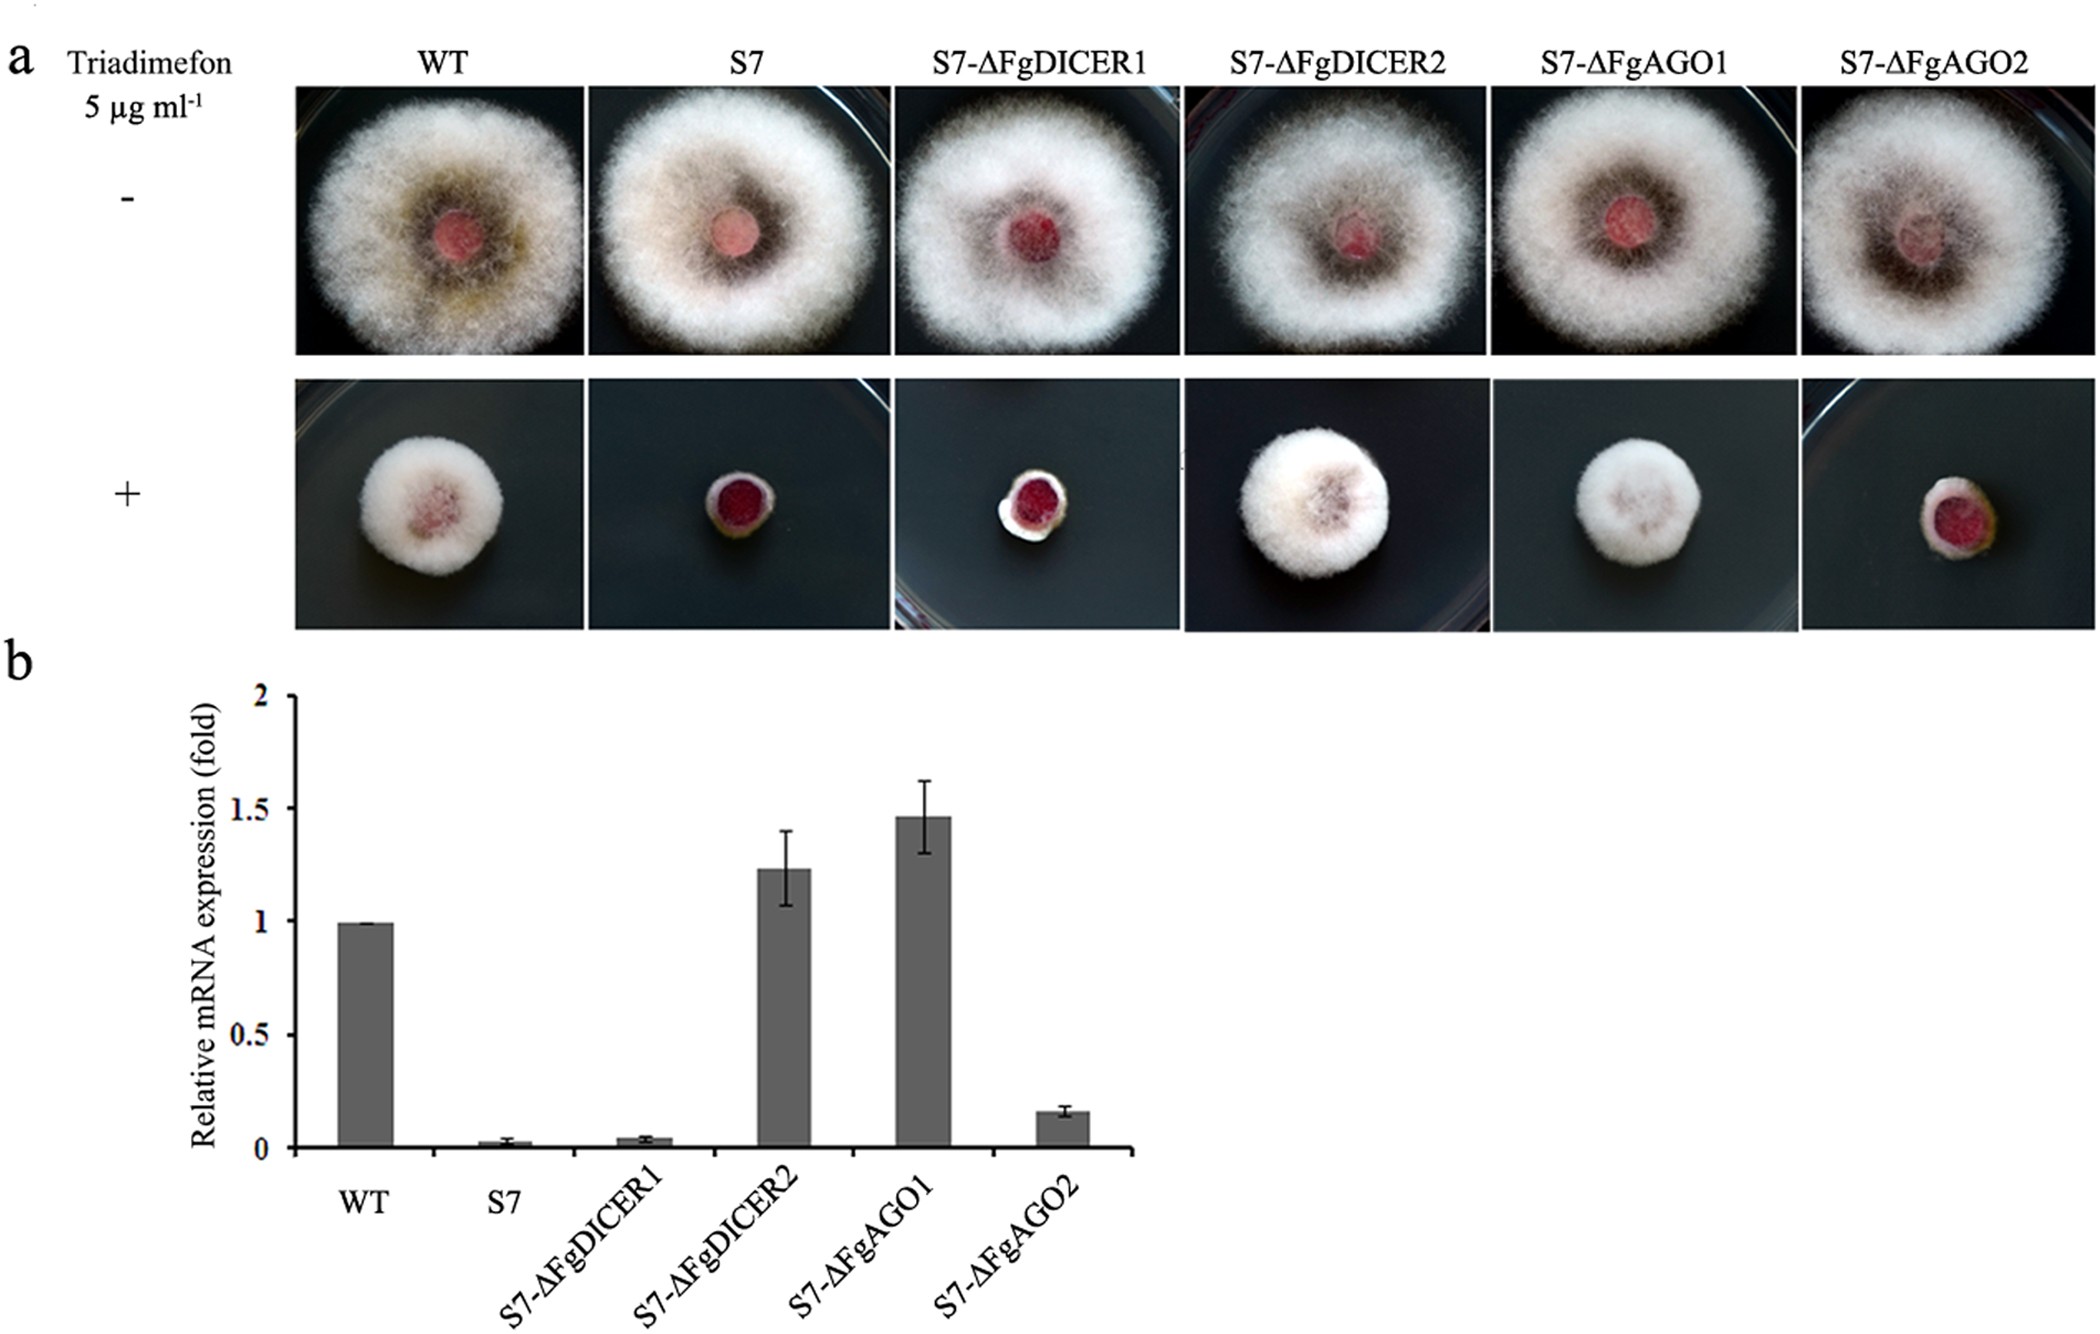
Figure 3

Figure 3
From: Characterization of RNA silencing components in the plant pathogenic fungus Fusarium graminearum
The role of argonautes and dicers in hpRNA-induced gene silencing in F. graminearum.
(a) Growth pattern of HN9-1, FgCYP51A gene silencing transformant FgCYP51A-S7, argonaute gene mutants in the FgCYP51A-S7 background (S7-∆FgAGO1 and S7-∆ FgAGO 2) and dicer gene mutants in the FgCYP51A-S7 background (S7-∆FgDICER1 and S7-∆FgDICER2) on PDA with or without DMI fungicide triadimefon (5 μg mL−1). The plate photographs were taken after 3 days of incubation at 25 °C. (b) The relative mRNA expression levels of FgCYP51A in the wild type, silencing transformant FgCYP51A-S7, S7-∆FgDICER1, S7-∆FgDICER2, S7-∆FgAGO1 and S7-∆FgAGO2 treated with triadimefon. Mycelia were collected after each strain was treated with 5 μg mL−1 triadimefon for 6 h, then the RNA extracted from each strain was used for quantitative RT-PCR assays. Expression of the actin gene was used as the reference. Line bars denote standard errors of three repeated experiments.